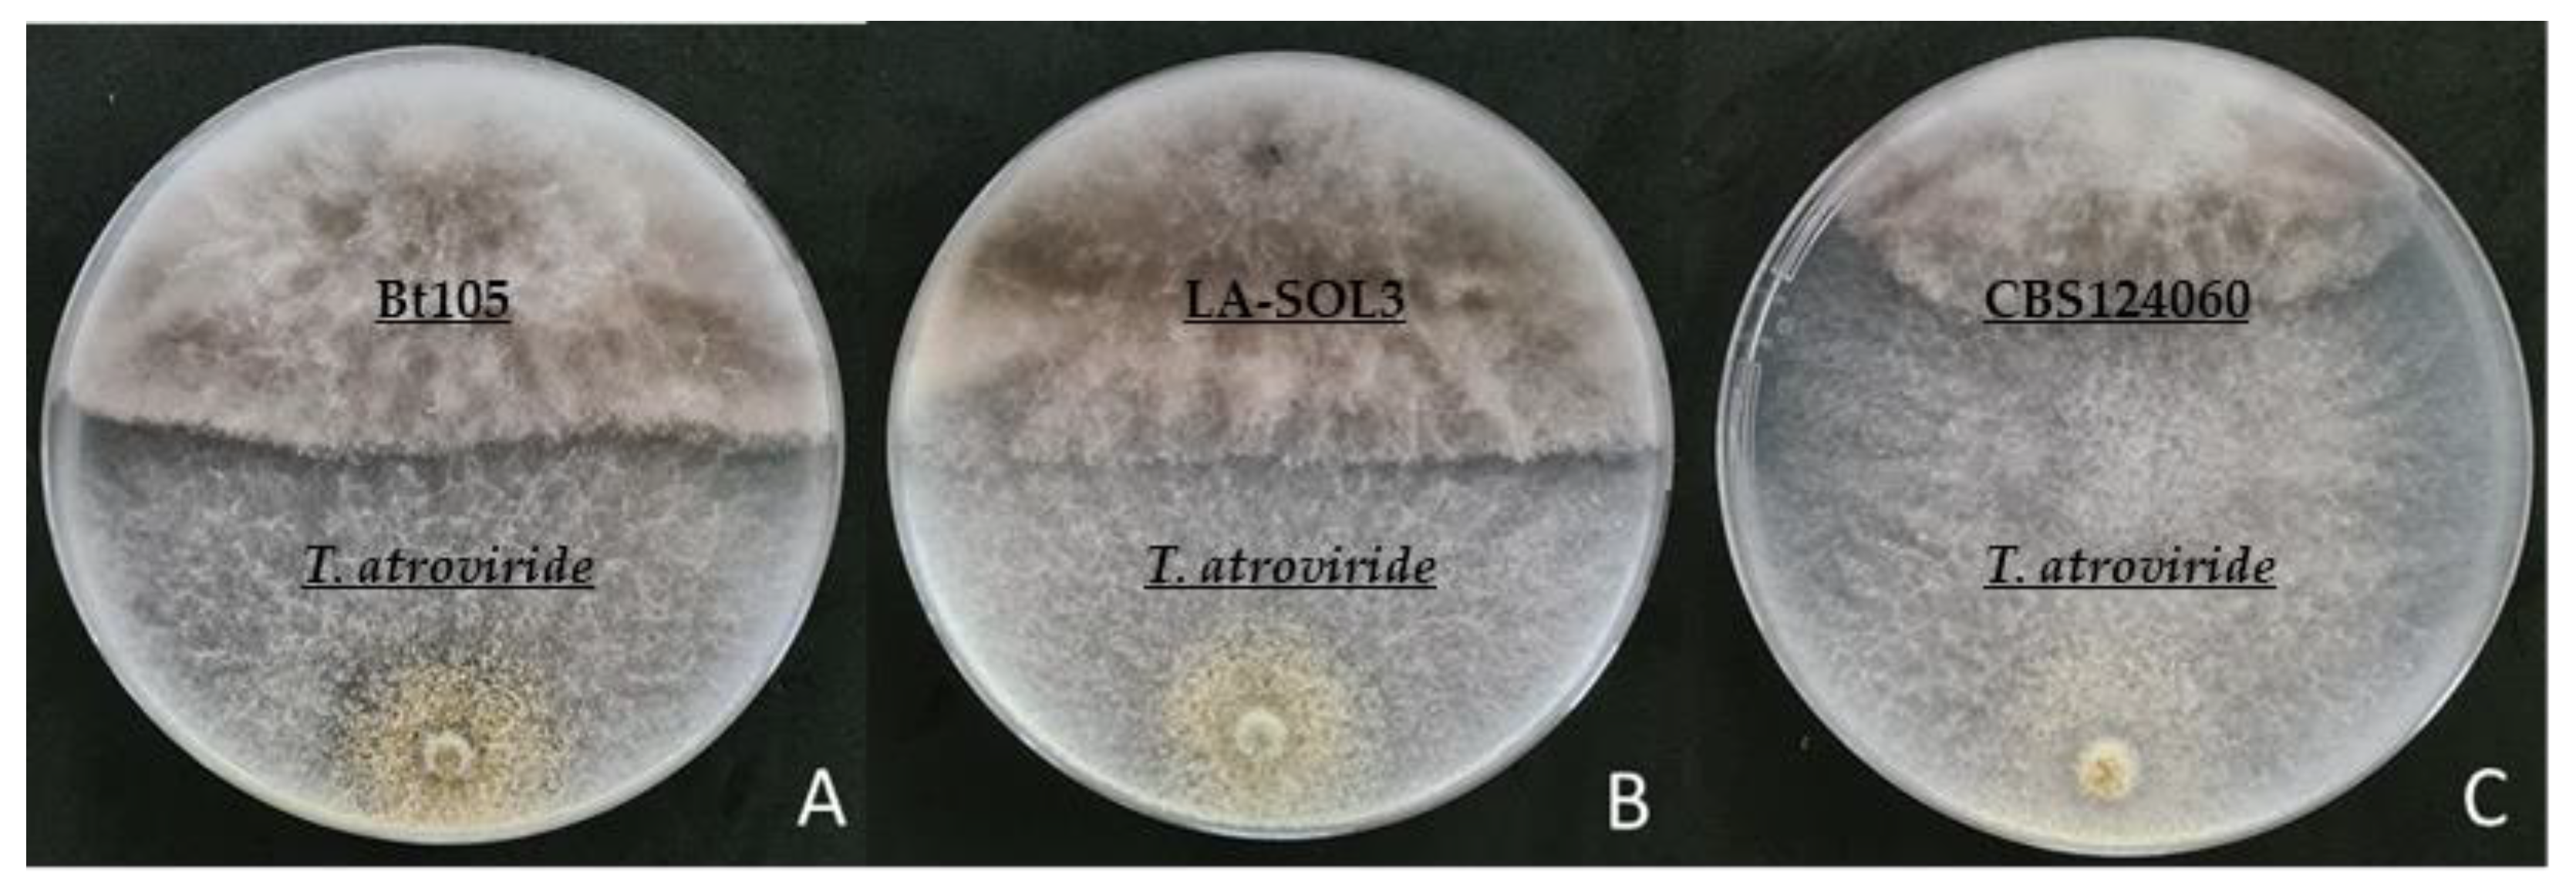

Combining an HA + Cu (II) Site-Targeted Copper-Based Product with a Pruning Wound Protection Program to Prevent Infection with Lasiodiplodia spp. in Grapevine
Abstract
1. Introduction
2. Results
2.1. In Vitro Assays
2.1.1. Mycelial Growth Inhibition Assays
2.1.2. Dual Culture Antagonism Assays
2.2. Field Assays
3. Discussion
3.1. Efficacy of Pruning Wound Protection Products Applied Alone
3.2. Efficacy of a Strategy Combining the Application of Pruning Wound Protectants with LC2017
4. Materials and Methods
4.1. In Vitro Assays
4.1.1. Mycelial Growth Inhibition Assay
4.1.2. Dual Culture Antagonism Assay
4.2. Field Assays
4.2.1. Experimental Field
4.2.2. Fungal Isolates Used and Inoculum Preparation
4.2.3. Experimental Design and Treatment Plan
4.2.4. Product Application and Pathogen Inoculation
4.2.5. Pathogen Recovery and Identification
4.2.6. Meteorological Data
4.2.7. Statistical Analysis
Author Contributions
Funding
Acknowledgments
Conflicts of Interest
References
- Gramaje, D.; Úrbez-Torres, J.R.; Sosnowski, M.R. Managing grapevine trunk diseases with respects to etiology and epidemiology: Current strategies and future prospects. Plant Dis. 2017, 102, 12–39. [Google Scholar] [CrossRef] [PubMed]
- Bertsch, C.; Ramirez-Suero, M.; Magnin-Robert, M.; Larignon, P.; Chong, J.; Abou-Mansour, E.; Spagnolo, A.; Clément, C.; Fontaine, F. Trunk diseases of grapevine: Complex and still poorly understood. Plant Pathol. 2012, 62, 243–265. [Google Scholar] [CrossRef]
- Kaplan, J.; Travadon, R.; Cooper, M.; Hillis, V.; Lubell, M.; Baumgartner, K. Identifying economic hurdles to early adoption of preventative practices: The case of trunk diseases in California winegrape vineyards. Wine Econ. Policy 2016, 5, 127–141. [Google Scholar] [CrossRef]
- Pitt, W.M.; Trouillas, F.P.; Gubler, W.D.; Savocchia, S.; Sosnowski, M.R. Pathogenicity of Diatrypaceous Fungi on Grapevines in Australia. Plant Dis. 2013, 97, 749–756. [Google Scholar] [CrossRef] [PubMed]
- Pitt, W.M.; Urbez-Torres, J.R.; Trouillas, F.P. Dothiorella and Spencermartinsia, new species and records from grapevines in Australia. Australas. Plant Pathol. 2014, 44, 43–56. [Google Scholar] [CrossRef]
- Rolshausen, P.E.; Akgül, D.S.; Perez, R.; Eskalen, A.; Gispert, C. First report of wood canker caused by Neoscytalidium dimidiatum on grapevine in California. Plant Dis. 2013, 97, 1511. [Google Scholar] [CrossRef] [PubMed]
- Úrbez-Torres, J.R. The status of Botryosphaeriaceae species infecting grapevines. Phytopathol. Mediterr. 2011, 50, S5–S45. [Google Scholar] [CrossRef]
- Yang, T.; Groenewald, J.Z.; Cheewangkoon, R.; Jami, F.; Abdollahzadeh, J.; Lombard, L.; Crous, P.W. Families, genera, and species of Botryosphaeriales. Fungal Biol. 2017, 121, 322–346. [Google Scholar] [CrossRef] [PubMed]
- Úrbez-Torres, J.R.; Leavitt, G.M.; Guerrero, J.C.; Guevara, J.; Gubler, W.D. Identification and Pathogenicity of Lasiodiplodia theobromae and Diplodia seriata, the Causal Agents of Bot Canker Disease of Grapevines in Mexico. Plant Dis. 2008, 92, 519–529. [Google Scholar] [CrossRef]
- Úrbez-Torres, J.R.; Gubler, W.D. Pathogenicity of Botryosphaeriaceae Species Isolated from Grapevine Cankers in California. Plant Dis. 2009, 93, 584–592. [Google Scholar] [CrossRef]
- Van Niekerk, J.M.; Crous, P.W.; Groenewald, J.Z.; Fourie, P.H.; Halleen, F. DNA Phylogeny, Morphology and Pathogenicity of Botryosphaeria Species on Grapevines. Mycologia 2004, 96, 781–798. [Google Scholar] [CrossRef]
- Pitt, W.M.; Huang, R.; Steel, C.C.; Savocchia, S. Pathogenicity and epidemiology of Botryosphaeriaceae species isolated from grapevines in Australia. Australas. Plant Pathol. 2013, 42, 573–582. [Google Scholar] [CrossRef]
- Rangel-Montoya, E.A.; Paolinelli, M.; Rolshausen, P.E.; Valenzuela-Solano, C.; Hernandez-Martinez, R. Characterization of Lasiodiplodia species associated with grapevines in Mexico. Phytopathol. Mediterr. 2021, 60, 237–251. [Google Scholar] [CrossRef]
- Linaldeddu, B.T.; Deidda, A.; Scan, B.; Franceschini, A.; Serra, S.; Berraf-Tebbal, A.; Zouaoui Boutiti, M.; Ben Jamâa, M.L.; Phillips, A.J.L. Diversity of Botryosphaeriaceae species associated with grapevine and other woody hosts in Italy, Algeria and Tunisia, with descriptions of Lasiodiplodia exigua and Lasiodiplodia mediterranea sp. Nov. Fungal Divers. 2015, 71, 201–214. [Google Scholar] [CrossRef]
- Zhang, W.; Groenewald, J.Z.; Lombard, L.; Schumacher, R.K.; Phillips, A.J.L.; Crous, P.W. Evaluating species in Botryosphaeriale. Pers. Mol. Phylogeny Evol. Fungi 2021, 46, 63–115. [Google Scholar] [CrossRef]
- Phillips, A.J.L.; Alves, A.; Abdollahzadeh, J.; Slippers, B.; Wingfield, M.J.; Groenewald, J.Z.; Crous, P.W. The Botryosphaeriaceae: Genera and species known from culture. Stud. Mycol. 2013, 76, 51–167. [Google Scholar] [CrossRef]
- Correia, K.C.; Câmara, M.; Barbosa, M.; Sales, R.; Agustí-Brisach, C.; Gramaje, D. Fungal trunk pathogens associated with table grape decline in Northeastern Brazil. Phytopathol. Mediterr. 2013, 52, 380–387. [Google Scholar]
- Urbez-Torres, J.R.; Peduto, F.; Striegler, R.K.; Urrea-Romero, K.E.; Rupe, J.C.; Cartwright, R.D.; Gubler, W.D. Characterization of fungal pathogens associated with grapevine trunk diseases in Arkansas and Missouri. Fungal Divers. 2012, 52, 169–189. [Google Scholar] [CrossRef]
- Yan, J.-Y.; Xie, Y.; Zhang, W.; Wang, Y.; Liu, J.-K.; Hyde, K.D.; Seem, R.C.; Zhang, G.-Z.; Wang, Z.-Y.; Yao, S.-W.; et al. Species of Botryosphaeriaceae involved in grapevine dieback in China. Fungal Divers. 2013, 61, 221–236. [Google Scholar] [CrossRef]
- Taylor, A.; Hardy, G.E.S.J.; Wood, P.; Burgess, T. Identification and pathogenicity of Botryosphaeria species associated with grapevine decline in Western Australia. Australas. Plant. Pathol. 2005, 34, 187–195. [Google Scholar] [CrossRef]
- Arkam, M.; Alves, A.; Lopes, A.; Čechová, J.; Pokluda, R.; Eichmeier, A.; Zitouni, A.; Mahamedi, A.E.; Berraf-Tebbal, A. Diversity of Botryosphaeriaceae causing grapevine trunk diseases and their spatial distribution under different climatic conditions in Algeria. Eur. J. Plant Pathol. 2021, 1–20. [Google Scholar] [CrossRef]
- Kaiser, W.; Rivero, V.; Valverde, B.E. First report of Diplodia cane dieback of grapevine in Bolivia. Plant Dis. 2009, 93, 320. [Google Scholar] [CrossRef] [PubMed]
- Burruano, S.; Mondello, V.; Conigliaro, G.; Alfonzo, A.; Spagnolo, A.; Mugnai, L. Grapevine decline in Italy caused by Lasiodiplodia theobromae. Phytopathol. Mediterr. 2008, 47, 132–136. [Google Scholar]
- Galvez, E.R.; Maldonado, E.; Alves, A. Identification and pathogenicity of Lasiodiplodia theobromae causing dieback of table grapes in Peru. Eur. J. Plant Pathol. 2015, 141, 477–489. [Google Scholar] [CrossRef]
- Rego, C.; Nascimento, T.; Pinto, P.; Oliveira, H. First report of Lasiodiplodia theobromae associated with cankers and dieback of grapevine (Vitis vinifera) in Portugal. In Proceedings of the 9th Conference of the European Foundation for Plant Pathology, Évora, Portugal, 15–18 November 2010. [Google Scholar]
- Aroca, A.; Raposo, R.; Gramaje, D.; Armengol, J.; Martos, S.; Luque, J. First Report of Lasiodiplodia theobromae Associated with Decline of Grapevine Rootstock Mother Plants in Spain. Plant Dis. 2008, 92, 832. [Google Scholar] [CrossRef][Green Version]
- Akgül, D.S.; Savas, N.G.; Eskalen, A. First Report of Wood Canker Caused by Botryosphaeria dothidea, Diplodia seriata, Neofusicoccum parvum, and Lasiodiplodia theobromae on Grapevine in Turkey. Plant Dis. 2014, 98, 568. [Google Scholar] [CrossRef]
- Mondello, V.; Battiston, E.; Pinto, C.; Coppin, C.; Trotel-Aziz, P.; Clément, C.; Mugnai, L.; Fontaine, F. Grapevine trunk diseases: A review of fifteen years of trials for their control with chemicals and biocontrol agents. Plant Dis. 2018, 102, 1189–1217. [Google Scholar] [CrossRef] [PubMed]
- Reis, P.; Gaspar, A.; Alves, A.; Fontaine, F.; Lourenco, I.; Saramago, J.; Mota, M.; Rego, C. Early Season Symptoms on Stem, Inflorescences and Flowers of Grapevine Associated with Botryosphaeriaceae Species. Plants 2020, 9, 1427. [Google Scholar] [CrossRef]
- Úrbez-Torres, J.R.; Battany, M.; Bettiga, L.J.; Gispert, C.; McGourty, G.; Roncoroni, J.; Smith, R.J.; Verdegaal, P.; Gubler, W.D. Botryosphaeriaceae Species Spore-Trapping Studies in California Vineyards. Plant Dis. 2010, 94, 717–724. [Google Scholar] [CrossRef]
- Van Niekerk, J.M.; Calitz, F.J.; Halleen, F.; Fourie, P.H. Temporal spore dispersal patterns of grapevine trunk pathogens in South Africa. Eur. J. Plant Pathol. 2010, 127, 375–390. [Google Scholar] [CrossRef]
- Elena, G.; Luque, J. Pruning debris of grapevine as a potential inoculum source of Diplodia seriata, causal agent of Botryosphaeria dieback. Eur. J. Plant Pathol. 2016, 144, 803–810. [Google Scholar] [CrossRef]
- Sosnowski, M.R.; McCarthy, G. Economic impact of grapevine trunk disease management in Sauvignon Blanc vineyards of New Zealand. Wine Vitic. J. 2017, 32, 42–48. [Google Scholar]
- Pitt, W.M.; Sosnowski, M.R.; Huang, R.; Qiu, Y.; Steel, C.C.; Savocchia, S. Evaluation of Fungicides for the Management of Botryosphaeria Canker of Grapevines. Plant Dis. 2012, 96, 1303–1308. [Google Scholar] [CrossRef] [PubMed]
- Díaz, G.A.; Latorre, B.A. Efficacy of paste and liquid fungicide formulations to protect pruning wounds against pathogens associated with grapevine trunk diseases in Chile. Crop. Prot. 2013, 46, 106–112. [Google Scholar] [CrossRef]
- Amposah, N.T.; Jones, E.E.; Ridgeway, H.J.; Jaspers, M.V. Evaluation of fungicides for the management of Botryosphaeria dieback diseases of grapevines. Pest. Manag. Sci. 2012, 68, 676–683. [Google Scholar] [CrossRef] [PubMed]
- Sosnowski, M.R.; Mundi, M.C. Pruning wound protection strategies for simultaneous control of Eutypa and Botryosphaeira dieback in New Zealand. Plant. Dis. 2019, 103, 519–525. [Google Scholar] [CrossRef]
- Rego, C.; Reis, P.; Dias, A.; Correia, R. Field evaluation of fungicides against Botryosphaeria dieback canker and Phomopsis cane and leaf spot. Phytopathol. Mediterr. 2014, 53, 581–582. [Google Scholar]
- Bester, W.; Crous, P.W.; Fourie, P.H.; Crous, P.W.; Fourie, P.H. Evaluation of fungicides as potential grapevine pruning wound protectants against Botryosphaeria species. Australas. Plant Path. 2007, 36, 73–77. [Google Scholar] [CrossRef]
- Mutawila, C.; Halleen, F.; Mostert, L. Development of benzimidazole resistant Trichoderma strains for the integration of chemical and biocontrol methods of grapevine pruning wound protection. BioControl 2015, 60, 387–399. [Google Scholar] [CrossRef]
- Martínez-Diz, M.D.P.; Díaz-Losada, E.; Díaz-Fernández, Á.; Bouzas-Cid, Y.; Gramaje, D. Protection of grapevine pruning wounds against Phaeomoniella chlamydospora and Diplodia seriata by commercial biological and chemical methods. Crop. Prot. 2021, 143, 105465. [Google Scholar] [CrossRef]
- Rolshausen, P.E.; Úrbez-Torres, J.R.; Rooney-Lathman, S.; Eskalen, A.; Smith, R.J.; Gubler, W.D. Evaluation of pruning wound susceptibility and protection against fungi associated with grapevine trunk diseases. Am. J. Enol. Vitic. 2010, 61, 113–119. [Google Scholar]
- Epstein, L.; Sukhwinder, K.; VanderGheynst, J.S. Botryosphaeria-related dieback and control investigated in non-coastal California grapevines. Calif. Agric. 2008, 62, 161–166. [Google Scholar] [CrossRef]
- Wu, H.; Spagnolo, A.; Marivingt-Mounir, C.; Clément, C.; Fontaine, F.; Chollet, J.F. Evaluating the combined effect of systemic phenylpyrrole fungicide and the plant growth-promoting rhizobacteria Paraburkholderia pthytofirmans (strain PsJN:gfp2x) against the grapevine trunk pathogen Neofusicoccum parvum. Pest. Manag. Sci. 2020, 76, 3838–3848. [Google Scholar] [CrossRef] [PubMed]
- Fischer, J.; Beckers, S.J.; Yiamsawas, D.; Thines, E.; Landfester, K.; Wurm, F.R. Targeted drug delivery in plants: Enzyme-responsive lignin nanocarriers for the curative treatment of the worldwide grapevine trunk disease Esca. Adv. Sci. 2019, 6, 1802315. [Google Scholar] [CrossRef] [PubMed]
- Battiston, E.; Compant, S.; Antonielli, L.; Mondello, V.; Clément, C.; Simoni, A.; Di Marco, S.; Mugnai, L.; Fontaine, F. In planta Activity of Novel Copper(II)-Based Formulations to Inhibit the Esca-Associated Fungus Phaeoacremonium minimum in Grapevine Propagation Material. Front. Plant Sci. 2021, 12, 649694. [Google Scholar] [CrossRef] [PubMed]
- Battiston, E.; Salvatici, M.C.; Lavacchi, A.; Gatti, A.; Di Marco, S.; Mugnai, L. Functionalisation of a nano-structured hydroxyapatite with copper (II) compounds as pesticide: In situ TEM and ESEM observations of treated Vitis vinifera L. leaves. Pest. Man. Sci. 2018, 74, 1903–1915. [Google Scholar] [CrossRef] [PubMed]
- Mondello, V.; Fernandez, O.; Guise, J.-F.; Trotel-Aziz, P.; Fontaine, F. In planta Activity of the Novel Copper Product HA + Cu(II) Based on a Biocompatible Drug Delivery System on Vine Physiology and Trials for the Control of Botryosphaeria Dieback. Front. Plant Sci. 2021, 12, 693995. [Google Scholar] [CrossRef]
- Úrbez-Torres, J.R.; Tomaselli, E.; Pollard-Flamand, J.; Boulé, J.; Gerin, D.; Pollastro, S. Characterization of Trichoderma isolates from southern Italy, and their potential biocontrol activity against grapevine trunk disease fungi. Phytopathol. Mediterr. 2020, 59, 425–439. [Google Scholar]
- Berbegal, M.; Ramón-Albalat, A.; León, M.; Armengol, J. Evaluation of long-term protection from nursery to vineyard provided byTrichoderma atrovirideSC1 against fungal grapevine trunk pathogens. Pest Manag. Sci. 2020, 76, 967–977. [Google Scholar] [CrossRef]
- Mutawila, C.; Fourie, P.H.; Halleen, F.; Mostert, L. Grapevine cultivar variation to pruning wound protection by Trichoderma species against trunk pathogens. Phytopathol. Mediterr. 2011, 50, S264–S276. [Google Scholar]
- Mutawila, C.; Halleen, F.; Mostert, L. Optimisation of time of application of Trichoderma biocontrol agents for protection of grapevine pruning wounds. Aust. J. Grape Wine Res. 2016, 22, 279–287. [Google Scholar] [CrossRef]
- Mounier, E.; Boulisset, F.; Cortés, F.; Cadiou, M.; Dubournet, P.; Pajot, E. Esquive® WP limits development of grapevine trunk diseases and safeguards the production potential of vineyards. In Biocontrol of Major Grapevine Diseases: Leading Research; CABI: São Paulo, Brazil, 2016; pp. 160–170. [Google Scholar]
- Mounier, E.; Cortes, F.; Cadious, M.; Pajot, E. The benefits of Trichoderma atroviride strain I-1237 for the protection of grapevines against trunk diseases: From the nursery to the vineyard. Phytopathol. Mediterr. 2014, 53, 591–592. [Google Scholar]
- Reis, P.; Letousey, P.; Rego, C. Trichoderma atroviride strain I-1237 protects pruning wounds against grapevine wood pathogens. Phytopathol. Mediterr. 2017, 56, 580. [Google Scholar]
- Rusin, C.; Cavalcanti, F.R.; De Lima, P.C.G.; Faria, C.M.D.R.; Almança, M.A.K.; Botelho, R.V. Control of the fungi Lasiodiplodia theobromae, the causal agent of dieback, in cv. syrah grapevines. Acta Sci. Agron. 2020, 43, e44785. [Google Scholar] [CrossRef]
- Sosnowski, M.; Creaser, M.; Wicks, T.; Lardner, R.; Scott, E.S. Protection of grapevine pruning wounds from infection byEutypa lata. Aust. J. Grape Wine Res. 2008, 14, 134–142. [Google Scholar] [CrossRef]
- Sosnowski, M.R.; Ayres, M.; Wicks, T.; McCarthy, M.; Scott, E. In search of resistance to grapevine trunk diseases. Wine Vitic. 2013, 28, 55–58. [Google Scholar]
- Kotze, C.; van Niekerk, J.; Mostert, L.; Halleen, F.; Fourie, P.H. Evaluation of biocontrol agents for pruning wound protection against trunk pathogens infection. Phytopathol. Mediterr. 2011, 56, 536. [Google Scholar]
- John, S.; Wicks, T.J.; Hunt, J.S.; Lorimer, M.F.; Oakey, H.; Scott, E.S. Protection of grapevine pruning wounds from infection by Eutypa lata using Trichoderma harzianum and Fusarium lateritium. Australas. Plant. Pathol. 2005, 34, 569–575. [Google Scholar] [CrossRef]
- Halleen, F.; Fourie, P.; Lombard, P. Protection of Grapevine Pruning Wounds against Eutypa lata by Biological and Chemical Methods. S. Afr. J. Enol. Vitic. 2016, 31, 125–132. [Google Scholar] [CrossRef]
- Leal, C.; Richet, N.; Guise, J.F.; Gramaje, D.; Armengol, J.; Fontaine, F.; Trotel-Aziz, P. Cultivar contributes to the beneficial effects of Bacillus subtilis PTA-271 and Trichoderma atroviride SC1 to protect grapevine against Neofusicoccum parvum. Front. Microbiol. 2021, 12, 726132. [Google Scholar] [CrossRef]
- Pertot, I.; Caffi, T.; Rossi, V.; Mugnai, L.; Hoffmann, C.; Grando, M.S.; Gary, C.; Lafond, D.; Duso, C.; Thiery, D.; et al. A critical review of plant protection tools for reducing pesticide use on grapevine and new perspectives for the implementation of IPM in viticulture. Crop. Protect. 2017, 97, 70–84. [Google Scholar] [CrossRef]
- Rego, C.; Nascimento, T.; Cabral, A.; Silva, M.J.; Oliveira, H. Control of grapevine wood fungi in commercial nurseries. Phytopathol. Mediterr. 2009, 48, 128–135. [Google Scholar]
- Kühn, A.; Zappata, A.; Gold, R.E.; Zito, R.; Kortekamp, A. Susceptibility of grape pruning wounds to grapevine trunk diseases and effectiveness of a new BASF wound protectant. Phytopathol. Mediterr. 2017, 56, 536. [Google Scholar]
- Samaras, A.; Ntasioy, P.; Testempasis, S.; Theocharis, S.; Koundouras, S.; Karaoglanidis, G. Evaluation of the fungicide Tessior (boscalid and pyraclostrobin) for control of grapevine trunk diseases in Greece. Phytopathol. Mediterr. 2019, 58, 421. [Google Scholar]
- Lengyel, S.; Gold, R.E.; Fischer, J.; Yemelin, A.; Thines, E.; Kühn, A. Early detection project- detection and quantification of Phaeomoniella chlamydospora and Botryosphaeria spp. in Vitis vinifera wood samples. Phytopathol. Mediterr. 2019, 58, 406–407. [Google Scholar]
- van Niekerk, J.M.; Halleen, F.; Crous, P.W.; Fourie, P.H. The distribution and symptomatology of grapevine trunk pathogens are influenced by climate. Phytopathol. Mediterr. 2011, 50, S98–S111. [Google Scholar]
- Félix, C.; Duarte, A.S.; Vitorino, R.; Guerreiro, A.C.L.; Domingues, P.; Correia, A.C.M.; Alves, A.; Esteves, A.C. Temperature Modulates the Secretome of the Phytopathogenic Fungus Lasiodiplodia theobromae. Front. Plant Sci. 2016, 7, 1096. [Google Scholar] [CrossRef] [PubMed]
- Reis, P.; Gaspar, A.; Alves, A.; Fontaine, F.; Rego, C. Susceptibility of different grapevine cultivars to infection by Lasiodiplodia theobromae and Lasiodiplodia mediterranea. Plant. Dis. Under review.
- Sofia, J.; Mota, M.; Gonçalves, M.T.; Rego, C. Response of four Portuguese grapevine cultivars to infection by Phaeomoniella chlamydospora. Phytopatol. Mediterr. 2019, 57, 506–518. [Google Scholar]
- Battiston, E.; Antonielli, L.; Di Marco, S.; Fontaine, F.; Mugnai, L. Innovative Delivery of Cu(II) Ions by a Nanostructured Hydroxyapatite: Potential Application in Planta to Enhance the Sustainable Control of Plasmopara viticola. Phytopathology 2019, 109, 748–759. [Google Scholar] [CrossRef] [PubMed]
- Di Marco, S.; Osti, F.; Mugnai, L. First studies on the potential of a copper formulation for the control of leaf stripe disease within Esca complex in grapevine. Phytopathol. Mediterr. 2011, 50, 300–309. [Google Scholar]
- Aziz, A.; Trotel-Aziz, P.; Dhuicq, L.; Jeandet, P.; Couderchet, M.; Vernet, G. Chitosan Oligomers and Copper Sulfate Induce Grapevine Defense Reactions and Resistance to Gray Mold and Downy Mildew. Phytopathology 2006, 96, 1188–1194. [Google Scholar] [CrossRef]
- Rahman, M.A.; Begum, M.F.; Alam, M.F. Screening of Trichoderma isolates as a biological control agent against Ceratocystis paradoxa causing pineapple disease of sugar cane. Microbiology 2009, 37, 277–285. [Google Scholar]
- Crous, P.W.; Slippers, B.; Wingfield, M.J.; Rheeder, J.P.; Marasas, W.F.; Philips, A.J.; Alves, A.; Burgess, T.; Barber, P.; Groenewald, J.Z. Phylogenetic lineages in the Botryosphaeriaceae. Stud. Mycol. 2006, 55, 235–253. [Google Scholar] [CrossRef] [PubMed]
- Phillips, A. Botryosphaeria species associated with diseases of grapevines in Portugal. Phytopathol. Mediterr. 2002, 41, 3–18. [Google Scholar]
- Úrbez-Torres, J.R.; Leavitt, G.M.; Voegel, T.; Gubler, W.D. Identification and distribution of Botryosphaeria species associated with grapevine cankers in California. Plant. Dis. 2006, 90, 1490–1503. [Google Scholar] [CrossRef] [PubMed]
- Alves, A.; Crous, P.W.; Correia, A.; Phillips, A.J.L. Morphological and molecular data reveal cryptic speciation in Lasiodiplodia theobromae. Fungal Divers. 2008, 28, 1–13. [Google Scholar]
- White, T.J.; Bruns, T.; Lee, S.; Taylor, J. Amplified and direct sequencing of fungal ribosomal RNA genes for phylogenetics. In PCR Protocols: A Guide to Methods and Applications; Innis, M.A., Gelfand, D.H., Sninsky, J.J., White, T.J., Eds.; Academic: San Diego, CA, USA, 1990; pp. 315–322. [Google Scholar]
- Vaissie, P.; Monge, A.; Husson, F. Perform Factorial Analysis from ‘FactoMineR’ with a Shiny Application. 2021. Available online: https://CRAN.R-project.org/package=Factoshiny (accessed on 1 November 2021).

| LC 2017 Concentration | Mycelial Growth Inhibition (%) z | |||
|---|---|---|---|---|
| Bt105 | LA-SOL3 | CBS124060 | T. atroviride (I-1237) | |
| A (12.5 mL/L) | 100.0 a | 100.0 a | 100.0 a | 100.0 a |
| B (2.5 mL/L) | 14.5 b | 13.9 b | 15.0 b | 44.6 b |
| C (1.25 mL/L) | 10.4 c | 9.4 c | 10.6 c | 26.0 c |
| D (0.25 mL/L) | 8.0 cd | 6.2 d | 9.3 c | 9.9 d |
| E (0.125 mL/L) | 6.1 d | 5.1 d | 8.1 c | 9.2 d |
| F (0.025 mL/L) | 5.4 d | 3.7 d | 4.5 c | 3.9 e |
| Treatment | Product | Isolate | Cabernet Sauvignon | Touriga Nacional | ||||||
|---|---|---|---|---|---|---|---|---|---|---|
| 2019 | 2020 | 2019 | 2020 | |||||||
| MPR y | MPDC z | MPR | MPDC | MPR | MPDC | MPR | MPDC | |||
| 1 | Esquive + LC2017 | Bt105 | 55.0 abc | 18.5 | 40.0 bc | 48.4 | 52.5 abc | 25.0 | 57.5 abc | 9.0 |
| 2 | Esquive + LC2017 | LA-SOL3 | 42.5 abcde | 26.1 | 30.0 bc | 53.8 | 57.5 abc | 8.0 | 30.0 c | 58.6 |
| 3 | Esquive + LC2017 | CBS124060 | 17.5 de | 70.8 | 20.0 c | 60.0 | 60.0 abc | 20.0 | 40.0 bc | 48.4 |
| 4 | Tessior + LC2017 | Bt105 | 12.5 e | 81.5 | 25.0 c | 67.7 | 42.5 bc | 39.3 | 30.0 c | 52.5 |
| 5 | Tessior + LC2017 | LA-SOL3 | 22.5 bcde | 60.9 | 45.0 bc | 30.8 | 60.0 abc | 4.0 | 60.0 abc | 17.2 |
| 6 | Tessior + LC2017 | CBS124060 | 15.0 de | 75.0 | 35.0 bc | 30.0 | 57.5 abc | 23.3 | 62.5 ab | 19.4 |
| 7 | Tessior | Bt105 | 42.5 abcde | 37.0 | 37.5 bc | 51.6 | 52.5 abc | 25.0 | 42.5 bc | 32.8 |
| 8 | Tessior | LA-SOL3 | 12.5 e | 78.3 | 40.0 bc | 38.5 | 50.0 abc | 20.0 | 55.0 abc | 24.1 |
| 9 | Tessior | CBS124060 | 20.0 cde | 66.7 | 22.5 c | 55.0 | 65.0 abc | 13.3 | 42.5 bc | 45.2 |
| 10 | Esquive | Bt105 | 62.5 ab | 7.4 | 35.0 bc | 54.8 | 50.0 abc | 28.6 | 40.0 bc | 36.7 |
| 11 | Esquive | LA-SOL3 | 37.5 abcde | 34.8 | 40.0 bc | 38.5 | 32.5 c | 48.0 | 52.5 abc | 27.6 |
| 12 | Esquive | CBS124060 | 50.0 abcd | 16.7 | 20.0 c | 60.0 | 35.0 c | 53.3 | 65.0 ab | 15.0 |
| 13 | Inoculated Control | Bt105 | 67.5 a | - | 75.0 a | - | 70.0 ab | - | 65.0 ab | - |
| 14 | Inoculated Control | LA-SOL3 | 57.5 abc | - | 65.0 ab | - | 62.5 abc | - | 72.5 a | - |
| 15 | Inoculated Control | CBS124060 | 60.0 abc | - | 50.0 abc | - | 75.0 a | - | 77.5 a | - |
| Species | Isolates | Geographic Origin |
|---|---|---|
| L. theobromae | Bt105 | Alentejo, Portugal |
| LA-SOL3 | Sol Sol, Piura, Peru | |
| L. mediterranea | CBS 124060 | Sicily, Italy |
| Product Name | Manufacturer | Application Time | Application Rate | Active Ingredient |
|---|---|---|---|---|
| Esquive® | Idai Nature | After pruning | 4 kg/ha | Trichoderma atroviride strain I-1237 (1 × 108 CFU g−1) |
| Tessior® | BASF Agricultural Solutions Portugal | After pruning | n/a | Pyraclostrobin 0.48% + boscalid 0.95% |
| LC2017 | Natural development Group® | Immediately after harvest | 400 L/ha | Hydroxyapatite (HA) loaded with cooper (II) sulphate pentahydrate (CuSPHy + HA) |
| After pruning (Winter) | 250 L/ha | |||
| Four leaves developed | 250 L/ha | |||
| Summer pruning | 400 L/ha | |||
| Veraisson | 400 L/ha |
| Treatment | Product | Inoculation | Spore Solution Volume (µL) |
|---|---|---|---|
| 1 | Esquive + LC2017 | L. theobromae (Bt105) | 20 |
| 2 | Esquive + LC2017 | L. theobromae (LA-SOL3) | 20 |
| 3 | Esquive + LC2017 | L. mediterranea (CBS124060) | 20 |
| 4 | Tessior + LC2017 | L. theobromae (Bt105) | 20 |
| 5 | Tessior + LC2017 | L. theobromae (LA-SOL3) | 20 |
| 6 | Tessior + LC2017 | L. mediterranea (CBS124060) | 20 |
| 7 | Tessior | L. theobromae (Bt105) | 20 |
| 8 | Tessior | L. theobromae (LA-SOL3) | 20 |
| 9 | Tessior | L. mediterranea (CBS124060) | 20 |
| 10 | Esquive | L. theobromae (Bt105) | 20 |
| 11 | Esquive | L. theobromae (LA-SOL3) | 20 |
| 12 | Esquive | L. mediterranea (CBS124060) | 20 |
| 13 | Inoculated non treated Control | L. theobromae (Bt105) | 20 |
| 14 | Inoculated non treated Control | L. theobromae (LA-SOL3) | 20 |
| 15 | Inoculated non treated Control | L. mediterranea (CBS124060) | 20 |
Publisher’s Note: MDPI stays neutral with regard to jurisdictional claims in published maps and institutional affiliations. |
© 2021 by the authors. Licensee MDPI, Basel, Switzerland. This article is an open access article distributed under the terms and conditions of the Creative Commons Attribution (CC BY) license (https://creativecommons.org/licenses/by/4.0/).
Share and Cite
Reis, P.; Gaspar, A.; Alves, A.; Fontaine, F.; Rego, C. Combining an HA + Cu (II) Site-Targeted Copper-Based Product with a Pruning Wound Protection Program to Prevent Infection with Lasiodiplodia spp. in Grapevine. Plants 2021, 10, 2376. https://doi.org/10.3390/plants10112376
Reis P, Gaspar A, Alves A, Fontaine F, Rego C. Combining an HA + Cu (II) Site-Targeted Copper-Based Product with a Pruning Wound Protection Program to Prevent Infection with Lasiodiplodia spp. in Grapevine. Plants. 2021; 10(11):2376. https://doi.org/10.3390/plants10112376
Chicago/Turabian StyleReis, Pedro, Ana Gaspar, Artur Alves, Florence Fontaine, and Cecília Rego. 2021. "Combining an HA + Cu (II) Site-Targeted Copper-Based Product with a Pruning Wound Protection Program to Prevent Infection with Lasiodiplodia spp. in Grapevine" Plants 10, no. 11: 2376. https://doi.org/10.3390/plants10112376
APA StyleReis, P., Gaspar, A., Alves, A., Fontaine, F., & Rego, C. (2021). Combining an HA + Cu (II) Site-Targeted Copper-Based Product with a Pruning Wound Protection Program to Prevent Infection with Lasiodiplodia spp. in Grapevine. Plants, 10(11), 2376. https://doi.org/10.3390/plants10112376

